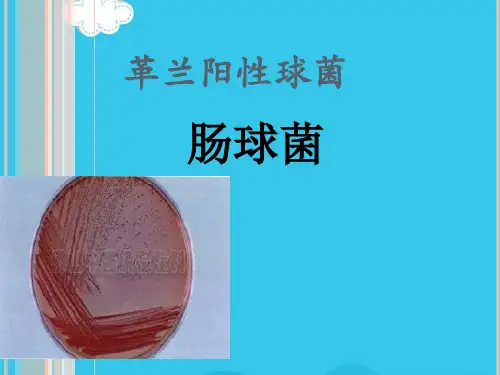

肠球菌耐药机制及用药分析
- 格式:doc
- 大小:30.00 KB
- 文档页数:4

医院多重耐药菌的耐药机制及防控措施作者:杜凤霞贾靖王艳鸿刘莉来源:《中国卫生产业》2017年第14期[摘要] 大量广谱抗生素的应用及抗生素的滥用打破了抗菌药物-细菌耐药的动态平衡,造成细菌耐药性增强。
多重耐药菌在医院的传播形势日益严重,也给医院感染控制带来严峻的挑战。
为保障医疗安全,让医务人员了解多重耐药菌的耐药机制,及早采取有效的防控措施,预防和控制多重耐药菌的传播和医院感染的发生。
该文针对多重耐药菌的耐药机制和防控措施进行了综述。
[关键词] 医院;多重耐药菌;耐药机制;防控措施[中图分类号] R515 [文献标识码] A [文章编号] 1672-5654(2017)05(b)-0195-02多重耐药菌的产生与流行已构成社会性危害,防控MDRO感染重于治疗。
研究多重耐药菌的耐药机制,有利于临床制定合理的治疗方案及多重耐药菌感染与传播预防策略[1]。
多重耐药菌的概念(MDRO)[2]:指对通常敏感的常用的3类或3类以上抗菌药物同时呈现耐药的细菌,临床常见多重耐药菌有耐甲氧西林金黄色葡萄球菌(MRSA)、耐万古霉素肠球菌(VRE)、产超广谱β-内酰胺酶(ESBLs)的细菌、耐碳青霉烯类肠杆菌科细菌(CRE)如耐碳青霉烯鲍曼不动杆菌(CR-AB)、产KPC的细菌、产NDM-1的细菌、多重耐药/泛耐药铜绿假单胞菌(MDR-PA)和艰难梭菌(CD)等。
1 常见多重耐药菌耐药机制1.1 艰难梭菌耐药机制艰难梭菌(CD)主要引起抗生素相关腹泻和假膜性肠炎,其感染发病率和病死率极高,尤其是多重耐药艰难梭菌,给临床的治疗带来极大的挑战。
目前,随着广谱抗菌药物的大量使用导致患者肠道菌群失调,极易引起艰难梭菌感染。
避免盲目使用广谱抗菌素,从而降低CD 感染的发生和传播。
2001年我国报道了1例多重耐药艰难梭菌感染的病例,绝大多数艰难梭菌菌株对甲硝唑、万古霉素、非达霉素仍呈敏感,但近来报道敏感性逐渐下降甚至呈现耐药,耐药机制可能为铁代谢、细菌DNA修复能力增强等多种因素有关。

肠球菌耐药情况和治疗选择WHO将耐万古霉素的肠球菌(VRE)作为优先级比较高的病原体来对待。
鉴定出多重耐药菌(MDR)的肠球菌很重要。
粪肠球菌和屎肠球菌能够引起危重病人的感染,而且其抗生素敏感性很复杂。
固有耐药肠球菌的抗生素敏感谱非常让人讨厌,它们对β内酰胺类抗生素有着天生的低维度的耐药。
肠球菌能够表达特异性的结合蛋白(pbp5),这种蛋白分布在细胞外膜上,它和β内酰胺类抗生素结合力很低,因而导致这类抗生素效果欠佳。
同时,肠球菌对氨基糖昔类有着天然的中等程度的耐药,这是因为肠球菌的细胞膜通透性很差,能够阻挡大分子抗生素进入到细菌体内。
此外,肠球菌对头孜菌素和克林霉素的耐药性较高。
除了最新研发出的新一代头泡菌素(对粪肠球菌有活性的头泡洛林),其他的几乎对肠球菌没有活性;即便是氨芾西林敏感的肠球菌,联合使用头电菌素进行治疗,都起不到协同作用。
欧洲分离出来的肠球菌中,30%对氨基糖甘类抗生素高度耐药(H1AR 株),这种耐药性可以通过对核糖体修饰或者产生氨基糖普修饰酶来实现。
中等程度的耐药可以联合使用β内酰胺(破坏细胞膜)和氨基糖昔来药物来治疗,但对H1AR株来讲,结果不一致。
获得性耐药之万古霉素在欧洲和美国,VanA操纵子型耐药是VRE重要的耐药机制(VRE的比例可以达到15%),VanA操纵子能够影响VanZ基因的表达,从而引起万古霉素和替考拉宁耐药。
澳大利亚的流行株多为VanB操作子型,这些病原菌身上缺少VanZ基因。
住院时间延长、ICU治疗、慢性肾功能不全和透析、腹部手术、侵袭性操作、万古霉素使用、美罗培南使用、氟喳诺酮使用、头匏曲松使用军事VRE产生的高危因素Q手卫生是阻断VRE交叉感染的重要手段。
肠球菌之间的耐药机制可以相互传播,从而导致菌体群体范围间的广泛耐药。
VRE株病原菌可以在人体持续存在数月甚至数年,从而引起反复感染,没有免疫抑制的患者复发感染的比例可达10%,有免疫缺陷的患者二次感染的比例可以高达35%。

肠球菌-病菌简介肠球菌肠球菌为院内感染的重要病原菌,不仅可引起尿路感染、皮肤软组织感染,还可引起危及生命的腹腔感染、败血症、心骨膜炎和脑膜炎,由于其固有耐药性,所致感染治疗困难。
本文就肠球菌的生物学特性、所致感染的临床表现、肠球菌在院内感染中的地位、致病性、耐药性及所致感染的治疗作一综述。
肠球菌(Enterococcus)属链球菌科,是人类和动物肠道正常菌群的一部分,通常在引起腹腔和盆腔感染所分离的混合菌丝中发现,既往认为肠球菌是对人类无害的共栖菌,但近年研究已证实了肠球菌的致菌力。
在需氧革兰阳性球菌中,它是仅次于葡萄球菌的重要院内感染致病菌[1],肠球菌亦可引起院外感染。
肠球菌不仅可引起尿路感染、皮肤软组织感染,还可引起危及生命的腹腔感染、败血症、心内膜炎和脑膜炎等[2]。
肠球菌-生物学特性及分类肠球菌为圆形或椭圆形、呈链状排列的革兰阳性球菌,无芽胞,无鞭毛,为需氧或兼性厌氧菌。
本菌对营养要求肠球菌较高,在含有血清的培养基上生长良好。
在血平板上经37℃培养18小时后,可形成灰白色、不透明、表面光滑、直径0.5~1mm大小的圆形菌落,不同的菌株表现为不同的溶血现象。
与同科链球菌的显著不同在于本菌在生化反应上能耐受高盐和胆汁培养基,并对许多抗菌药物表现为固有耐药。
根据其利用糖类的特征可将肠球菌分为3组[3,4]:第一组以鸟肠球菌(E.avium)为代表;第二组以粪肠球菌(E.faecalis)等;包括尿肠球菌(E.faecium)等;第三组以坚韧肠球菌(E.durans)为代表。
其中对人类致病者主要为粪肠球菌和尿肠球菌[3,5]。
在临床分离菌中粪肠球菌占85%~95%、尿肠球菌占5%~10%,其余少数为坚韧肠球菌和其他肠球菌。
肠球菌-临床表现尿路感染为粪肠球菌所致感染中最为常见的,绝大部分为院内感染。
据报道16%的院内尿路感染由肠球菌引起,肠球菌仅次于大肠杆菌居第2位[1]。
其发生多与留置导尿管、其他器械操作和尿路结构异常有关[3]。


40M ed i cal Laborat or y Sci t!nee a nd C l i ni cs。
2010。
vo也l。
N o.4医学检验与临床2010年第2l卷第4期院内感染肠球菌的临床感染特征及其耐药性分析马均宝凌步致崔东岚吴智刚(广东省佛山市第一人民医院检验科,佛山528000)【摘要】目的了解及分析肠球茵在医院感染中的临床感染特征与对药性,为临床正确选用抗茵药物提供科学依据,为减少院内感染的发生作出努力。
方法采用V I T E K全自动微生物分析仪、A T B半自动仪分析与手工相结合的方法,对本院2007年J一12月I I盏床送检标本进行培养分离鉴定,使用全自动分析仪M I C法与K i r by—B auer纸片扩散法相结合的方法测定其对抗生素的耐药性;采用W H O N ET5软件从临床感染、标本类别、细茵种类及耐药性等方面进行统计和分析。
结果全年检测肠球茵标本141例,其中粪肠球菌占70%,屎肠球茵27.6%,其他肠球菌2.4%;粪肠球菌对临床常见抗茵药物普遍耐药,以复方新诺明、头孢唑啉、克林霉素的耐药率最高,而敏感率最高的抗茵药物有替考拉宁、利奈唑脘、呋喃妥因、万古霉素。
屎肠球茵对除糖肽类抗生素以外的所有临床常用抗茵药物显示高水平耐药,以苯唑西林、丁胺卡那霉、复方新诺明、头孢I唑啉的耐药率最高,而敏感率最高的抗茵药物有利奈唑脘、替考拉宁、氯霉素、万古霉素。
耐万古霉素肠球茵(V R E)的阳性率也呈上升趋势。
结论开展肠球茵的耐药性监测,对遏止肠珠茵耐药株的增长,减缓其耐药率的增加,指导临床合理选用抗茵药物均有重要意义。
【关键词】肠球菌;抗茵药物;耐药性;V REA n al ys i s on cl i n i cal i nfe ct i on char ac t er i s t i c and dr u g re s i st a nce of E enf er o coccus i nfe ct i on i n hospi t al M a J un bao,L i ngB uzhi,C uD on6l an,W n Z h i gan g(D epar t m en t of C l i n i cal L abor at or y,t he F i r st Peop l e’s H os pit al of Fosha n,G uangdong.Foshan,528000)【A b st r act]O bj ect i ve U nd er st a ndi ng a nd anal ysi s of ent er o cocens i n f e c ti on s i n t he ho s pi t al w it h t he cl i ni c a l f eat ures and r esi s t an ce t o a il.t i bi ot i CS of choi ce of t he ri ght t o pr ovi de a sc i ent i fi c bas is.t o r edu ce t he i nci dene e of nosoc om i al i nf ec t ions ef f or t s.M et hods V r I EK anm m a f i c u s e of m i cr obi al an al ys is i n st r u m en t.A T B—sem i—a ut o m at i c a nd nl肌ual an al ys is of t he m e t ho d of co m bi n i ng t he ho s pi t al i n20071t o D ecem ber c l i ni cal sp eci m ens s ent for cult ur e i sola t ion and i dent i fi cati on.t he u s e of aut om at i c analyzer M I C l aw and t he K i r by—Baue r pap er C om bi nat i on of t he s pr ead of t he m e t ho d of i t s r esi s t an ce t o ant i bi o t i cs;W HO N E'13us ing s oft w ar e f r om t he anal ysi s of c l i ni cal i nf ect i on,t he t yp e s of sp eci m ens,an d dr ug r es i st a nce of bact er i a,and ot her as pect s of st at i st i c s a nd analys i s.R es ul t s N os oeom i al i nf ect i on i n t he w h ol e year'w er e141c8s e8of ent er oeocc i,w hi ch acc ount ed f or70per c entof E nt er ococ cus f ae c al is and E nt e r ococ eus f eces27.6%,ot her ent er oeocei of2.4 per cen t of t heE nt e r ocoe cns f ae ca l is e ol ni non a n t i b i oti c s gen er all y r es i s t a n t t o t he new hospi tal c om pound M i ng,eef az ol i n,c l i ndam y ci n of t he hi ghes t r at es of dr ug r esi st an ce,and t he hi g hes t r at e of anti bi oti c—s ens i t ive dr ugs t ei co pl ani n,hne zohd W an,ni t r of ur an t oi n,van com yci n,I{e—s ui t.E nt e r ocoecus r i ght r i ght f eces i n ad di“o n t o sugar pept i de ant i bi ot i cs ot her t han t he c om m onl y us ed a n t i b i oti c s al l c l i ni cal di s pl ay hi gh—l evel r es i s ta nce t o m ethi eil l i n peni ci l l i n,am i kaci n m ycophenol a t e,sul f am et hoxazol e,eef azol i n r es i st a nce The hi ghes t r at e,t he hi ghes t r at e of ant ibi ot i c—s ensi t i ve dr ugs l inez oli d W an,t ei co pl ani n,chl or am phen i c01.vancom yci n.I nt est i nal va ncom yci n—r e si st ant,en t er o eoec i(V RE)t h e r esi s t an ce r at e r i se.C oncl u si on Survei l l ance of bact eri al r es i st a nce t o t he r at ional dr ug u∞.i m pr ov e t he e ff i ca cy a nd s l o w dow n r e si s t a n c e i s i m port ant.【K ey w ords]E nt erococ cus;Ant i m i c m bi a l;D rug r es i st a nce;V R E肠球菌为条件致病菌,广泛分布于自然界中,是空气、水、尘埃、人及动物肠道上呼吸道的常居菌。

肠球菌耐药性分析目的分析本地区肠球菌的耐药情况和临床分布特点,以便了解其感染状况,指导临床合理使用抗菌药物并防止其导致的医院内感染的流行。
方法收集2009年10月~2011年9月在本院分离的各类患者的非重复菌株,采用药敏纸片扩散法(κ-B法),对实验菌株进行药敏实验。
结果肠球菌对替考拉宁(TEC)全部敏感,对呋喃妥因较为敏感,敏感率为91.25%~95.83%,对红霉素(ERY)的耐药率为82.4%~96.3%;对四环素(TET)耐药率为70.3%~73.2%;对氨芐西林(AMP)和青霉素(PEN)耐药比较接近,为23.5%~30%;对抗生素的耐药率的分析结果显示,除氯霉素(CHL)外,屎肠球菌明显高于粪肠球菌。
结论肠球菌属因存在种间的差异,抗生素耐药性也有所不同,同时,肠球菌的耐药性也比较严重,应引起高度重视。
标签:肠球菌;基因型;纸片扩散法;耐药性肠球菌是广泛存在于人和动物消化道及自然界中的一种条件致病菌。
既往认为是一种对人类健康无害的革兰氏阳性球菌。
二十世纪八十年代以来,由于临床中抗生素的广泛使用及免疫抑制剂的大应使用等因素的影响,导致肠球菌感染不断增加,并且由于肠球菌的固有耐药和获得性耐药,从临床分离的标本中耐药性的增加,出现多重耐药,使许多常用抗菌药物在治疗肠球菌感染时失败[1-2]。
因此,对肠球菌的药物敏感性研究也引起越来越多的科学家的重视。
为了给临床治疗提供帮助,选择2009年10月~2011年9月本院分离到的200株肠球菌菌株进行体外抗菌活性检测并加以分析。
现报道如下:1 资料与方法1.1 菌株来源选择2009年10月~2011年9月从本院各科室送检的的标本中分离非重复肠球菌菌株200株,其中,住院患者146株,门诊患者54株。
主要来源的标本来自尿液115株来自尿液,占57.5%,皮肤软组织创面分泌物及外科切口分泌物70株,占35%,血液10株,腹腔、胸腔引流液及胸腹腔积液5株。



常见耐药致病菌及抗菌药物选择1、耐甲氧西林金黄色葡萄球菌(MRSA)万古霉素是治疗MRSA和肠球菌感染的首选抗生素。
MRSA全身性感染可选用糖肽类的万古霉素、替考拉宁,或依药敏加用利福平、磷霉素等。
虽然糖肽类抗生素是抗MRSA最有效的药物,但随其广泛应用和不合理用药,已有耐万古霉素金黄色葡萄球菌出现。
半合成链阳菌素类新药Synercid(由喹奴普汀quinupristin 和达福普汀dafopristin两药以30:70比例混合而成)对其他药物治疗无效的MRSA(包括耐万古霉素的MRSA)有较好疗效。
Ⅲ期临床试验表明对MRSA感染有效率达91%。
新研究的碳青霉烯类BO-3482抗MRSA活性与万古霉素相同;唑烷酮类新药Linezolid对MRSA 同样有效。
2、耐万古霉素肠球菌(VRE)肠球菌是人和动物肠内的正常菌群,该菌是条件致病菌,可引起亚急性细菌性心内膜炎、菌血症、腹腔和尿道感染。
近年来越来越多的成为医院内感染的主要致病菌。
肠球菌由于其细胞壁坚厚,对许多抗菌药物表现为有耐药。
肠球菌对青霉素耐药机制为细菌产生一种特殊的青霉素结合蛋白(PBP5),与青霉素亲合力降低而导致耐药,此种耐药性以屎肠球菌多见。
近年来肠球菌对β-内酰胺类及氨基糖苷类抗生素耐药性严重,特别是由于临床上大量使用万古霉素及其不合理用药,导致耐万古霉素肠球菌(VRE)的出现。
肠球菌对糖肽类耐药主要是由于靶位改变,通过质粒和转座子将耐药基因从一种肠球菌染色体转移到另一种肠球菌染色体中。
目前尚无理想的治疗VRE感染药物,普遍采用联合用药,如氨苄西林+高浓度庆大霉素或链霉素、环丙沙星+高浓度庆大霉素+磷霉素等。
根据VRE临床药敏试验,如对西林类耐药可选用环丙沙星+庆大霉素+磷霉素;如对氨基糖苷类耐药可用替考拉宁+环丙沙星。
对于多重耐药菌株可选用抗菌新药如喹奴普汀/达福普汀(Quinupristin/Dalfoprision),此药对VRE有良好活性。
耐万古霉素肠球菌的耐药机制及耐药基因调控的研究进展姚杰;徐元宏【摘要】耐万古霉素肠球菌现已成为重要的医院感染病原菌,其对万古霉素耐药方式分为获得性耐药和先天性耐药,其中获得性耐药的类型包括VanA、VanB、VanD、VanG和VanE,先天性耐药的类型有VanC1/C2/C3.本文针对耐万古霉素肠球菌的耐药机制及其耐药基因的调控进行综述,以供参考.【期刊名称】《国外医药(抗生素分册)》【年(卷),期】2010(031)001【总页数】5页(P24-28)【关键词】肠球菌属;万古霉素;耐药机制【作者】姚杰;徐元宏【作者单位】安徽医科大学第一附属医院检验科,合肥230032;安徽医科大学第二附属医院检验科,合肥,230601;安徽医科大学第一附属医院检验科,合肥230032【正文语种】中文【中图分类】R978.1+9肠球菌属广泛分布在自然界,常栖居在人、动物的肠道和女性生殖道,是人类的正常菌群之一。
自从用抗菌药物治疗人类感染性疾病以来,肠球菌在抗菌药物的影响下,也逐渐形成了多重高水平耐药菌。
近年来,由于免疫抑制剂的广泛应用,侵入性治疗的增加,以及氟喹诺酮类和头孢菌素类药物的过度使用等因素使肠球菌感染不断增加,已成为医院感染的主要病原菌[1]。
可导致人体多脏器的感染,不仅可引起尿路感染、皮肤软组织感染,还可引起危及生命的腹腔感染、败血症、心内膜炎和脑膜炎等疾病,病死率达到21.0%~27.5%[2]。
自20世纪50年代晚期万古霉素用于临床以后,糖肽类抗生素即用于治疗和预防由革兰阳性细菌引起的严重疾病,并获得了一定的疗效。
1986年首次报道质粒介导的对万古霉素耐药肠球菌,以后耐药菌株迅速波及世界各地,且耐药菌株的产生逐渐增加,个别医院中甚至高达20%。
对万古霉素耐药的菌株多见于屎肠球菌,而在粪肠球菌中较少见。
由于该菌对糖肽类抗生素的固有耐药,可发展成为多重耐药,给临床治疗带来很大的困难,因此糖肽类抗生素耐药菌株对临床微生物学和流行病学提出了新的挑战。
肠杆菌科细菌最常见的耐药机制摘要:1.肠杆菌科细菌概述2.肠杆菌科细菌的耐药机制3.碳青霉烯类抗菌药物对肠杆菌科细菌的耐药性分析4.肠杆菌科细菌耐药性的变迁特点5.探讨肠杆菌科细菌耐药机制的研究方法正文:1.肠杆菌科细菌概述肠杆菌科细菌是一类广泛存在于自然环境中的细菌,主要生活在水和土壤中。
其中,大部分肠杆菌科细菌对人体无害,但部分细菌可引起人类疾病,如腹泻、败血症等。
近年来,随着抗生素的广泛使用,肠杆菌科细菌的耐药性问题日益严重,给临床治疗带来了很大困难。
2.肠杆菌科细菌的耐药机制肠杆菌科细菌的耐药机制多种多样,主要包括以下几个方面:(1)产β-内酰胺酶:β-内酰胺酶是一类可以水解β-内酰胺类抗生素的酶,如头孢菌素、青霉素等。
肠杆菌科细菌通过产生β-内酰胺酶,降低抗生素的活性,从而产生耐药性。
(2)药物外排泵:药物外排泵是一种可以将抗生素从细胞内泵到细胞外的膜转运蛋白,通过增强抗生素的排出,降低细胞内抗生素浓度,从而产生耐药性。
(3)靶位改变:抗生素通常通过作用于细菌的特定靶位,干扰细菌的正常生理功能,从而达到抑菌或杀菌作用。
部分肠杆菌科细菌通过改变抗生素作用靶位,降低抗生素的抑菌效果,产生耐药性。
(4)增强药物代谢:肠杆菌科细菌通过增强药物代谢酶的活性,加速抗生素在体内的代谢,降低抗生素浓度,从而产生耐药性。
3.碳青霉烯类抗菌药物对肠杆菌科细菌的耐药性分析碳青霉烯类抗菌药物,如亚胺培南、美罗培南等,具有较好的通透性和广谱抗菌活性,但对部分肠杆菌科细菌的耐药性较高。
近年来,对碳青霉烯类抗菌药物的耐药率逐渐上升,给临床治疗带来了很大挑战。
4.肠杆菌科细菌耐药性的变迁特点肠杆菌科细菌耐药性的变迁特点主要表现在以下几个方面:(1)对不同抗生素的耐药率有所不同:部分肠杆菌科细菌对某些抗生素的耐药率较高,而对另一些抗生素的耐药率较低。
(2)耐药率随时间的推移逐渐上升:随着抗生素的广泛使用,肠杆菌科细菌的耐药率逐渐上升,部分细菌甚至对多种抗生素产生了多重耐药性。
肠球菌耐药机制及用药分析肠球菌的多重耐药已给临床治疗造成困难,由此对肠球菌的耐药新研究已成为针对临床治疗的焦点。
治疗肠球菌感染应根据肠球菌的最新流行病学资料及耐药特点来选择相应的治疗方案。
标签:肠球菌β-内酰胺类抗生素氨基甙类万古霉素肠球菌的耐药机制比较复杂,总的来说,它对多种抗生素呈天然耐药和获得性耐药,其耐药发生机理有对药物的天然耐受;灭活酶的产生;青霉素结合蛋白的改变。
而长期接受抗生素治疗,特别是三代头孢的广泛使用;患者机体状况较差如肿瘤、糖尿病。
肾病以及免疫抑制剂的使用;长时间住院治疗,并使用广谱抗菌药;长时间化疗而引起的免疫力低下或中性粒细胞减少症等;长时间口服甲硝唑等是耐药株产生的因素。
2肠球菌对β-内酰胺类抗生素完全或相对耐药,对青霉素的敏感性较差,对头孢耐药。
肠球菌对青霉素的主要机制为细菌产生一种特殊的青霉素结合蛋白(pbp5),后者与青霉素的亲和力降低,从而导致耐药。
此种耐药以屎肠球菌多见。
青霉素不能致肠球菌自溶,因此对肠球菌而言,青霉素为抑菌作用,而非杀菌作用。
少数情况下,细菌产生大量青霉素酶而引起耐药,但通常用头孢硝噻吩纸片不易获得阳性结果,因此其确切发生可能被低估。
3肠球菌对氨基甙类的耐药性有2种:①中度耐药性(MIC62-500mg/L)系细胞壁渗透障碍所致,此种耐药菌对青霉素或糖甙类与氨基酸糖甙类合用敏感;②高级耐药性(庆大霉素MIC≥500mg/L、链霉素≥2000mg/L),系细菌产生质粒介导的氨基糖甙类的钝化酶所致,此种耐药使青霉素或糖肽类与氨基糖苷类的协同作用消失。
虽然体外药敏显示肠球菌对磺胺甲恶唑-甲氧苄啶敏感,但由于体内肠球菌可利用外源叶酸,故使该药失去抗菌作用。
4肠球菌对万古霉素的耐药性有3种:①VanA型,对万古霉素、壁霉素均高度耐药。
②VanB,对万古霉素呈不同程度耐药。
③Van型,本型少见且无临床意义。
5治疗肠球菌感染应根据肠球菌的最新流行病学资料及耐药特点来选择相应的治疗方案。
肠球菌耐药机制及用药分析
(山东省莱芜市人民医院山东莱芜271100)【摘要】肠球菌的多重耐药已给临床治疗造成困难,由此对肠球菌的耐药新研究已成为针对临床治疗的焦点。
治疗肠球菌感染应根据肠球菌的最新流行病学资料及耐药特点来选择相应的治疗方案。
【关键词】肠球菌β-内酰胺类抗生素氨基甙类万古霉素【中图分类号】r378 【文献标识码】a【文章编号】1004-5511(2012)04-0023-01 肠球菌原属于链球菌属,20世纪80年代,基于遗传学特征,人们将其从链球菌属分离出来,定义为肠球菌属,以前曾认为肠球菌是对人类无害的共栖菌,但是近年来由于三代头孢的大量应用等因素,其在革兰氏阳性球菌中已成为仅次于葡萄球菌属细菌的重要医院感染病
原菌。
肠球菌所致的感染中最常见的是泌尿系感染,其次是腹部、盆腔等部位的创伤和外科手术后感染,以及引起细菌性心内膜炎和败血症、新生儿脑膜炎。
肠球菌的多重耐药已给临床治疗造成困难,由此对肠球菌的耐药新研究已成为针对临床治疗的焦点。
1
肠球菌的耐药机制比较复杂,总的来说,它对多种抗生素呈天然耐药和获得性耐药,其耐药发生机理有对药物的天然耐受;灭活酶的产生;青霉素结合蛋白的改变。
而长期接受抗生素治疗,特别是三代头孢的广泛使用;患者机体状况较差如肿瘤、糖尿病。
肾病以及免疫抑制剂的使用;长时间住院治疗,并使用广谱抗菌药;长时间化疗而引起的免疫力低下或中性粒细胞减少症等;长时间口服甲
硝唑等是耐药株产生的因素。
2
肠球菌对β-内酰胺类抗生素完全或相对耐药,对青霉素的敏感性较差,对头孢耐药。
肠球菌对青霉素的主要机制为细菌产生一种特殊的青霉素结合蛋白(pbp5),后者与青霉素的亲和力降低,从而导致耐药。
此种耐药以屎肠球菌多见。
青霉素不能致肠球菌自溶,因此对肠球菌而言,青霉素为抑菌作用,而非杀菌作用。
少数情况下,细菌产生大量青霉素酶而引起耐药,但通常用头孢硝噻吩纸片不易获得阳性结果,因此其确切发生可能被低估。
3
肠球菌对氨基甙类的耐药性有2种:①中度耐药性
(mic62-500mg/l)系细胞壁渗透障碍所致,此种耐药菌对青霉素或糖甙类与氨基酸糖甙类合用敏感;②高级耐药性(庆大霉素mic ≥500mg/l、链霉素≥2000mg/l),系细菌产生质粒介导的氨基糖甙类的钝化酶所致,此种耐药使青霉素或糖肽类与氨基糖苷类的协同作用消失。
虽然体外药敏显示肠球菌对磺胺甲恶唑-甲氧苄啶敏感,但由于体内肠球菌可利用外源叶酸,故使该药失去抗菌作用。
4
肠球菌对万古霉素的耐药性有3种:①vana型,对万古霉素、壁霉素均高度耐药。
②vanb,对万古霉素呈不同程度耐药。
③van型,本型少见且无临床意义。
5
治疗肠球菌感染应根据肠球菌的最新流行病学资料及耐药特点
来选择相应的治疗方案。
对一般的粪肠球菌引起的感染可选用β-内酰胺类抗生素(青霉素或氨苄西林),严重感染者采用大剂量的
青霉素或氨苄西林联合氨基糖苷类药物,如已氨苄西林耐药,应选用含β-内酰胺酶抑制剂的药物(氨苄西林/舒巴坦、阿莫西林/克拉维酸等)与氨基糖苷类联合用药;对高浓度庆大霉素耐药的肠球菌感染,在体外药敏指导下用药,必要时可用万古霉素或替考拉宁。
治疗屎肠球菌引起的感染避免使用青霉素或氨苄西林,也不能使用含β-内酰胺酶抑制剂的药物,因为屎肠球菌属于不产青霉素酶的青霉素耐药肠球菌;如考虑和氨基糖苷类联合用药,应在体外药敏指导下用药,因为对高浓度庆大霉素的耐药率已达81.25%。
现已发现屎肠球菌对四环素耐药率低于氨苄西林、环丙沙星及氯霉素,因此治疗屎肠球菌引起的感染应考虑四环素。
不论是治疗粪肠球菌还是屎肠球菌引起的重症院内感染万古霉素仍然是疗效最好的药物。
如万古霉素中介或耐药可改用替考拉宁治疗。
对糖肽类药物耐药的肠球菌引起的感染,目前尚未有理想的治疗过方法[1]。
有文献报道[2],利奈唑胺和奎奴普丁-达福普丁药物对糖肽类药物耐药的肠球菌引起的感染疗效较好。
对泌尿系感染应首选呋喃妥因,因为肠球菌对呋喃妥因的耐药率仅高于糖肽类药物。
此外,环丙沙星与氨苄西林联用或环丙沙星与新霉素联用,环丙沙星与庆大霉素、利福平等联用都显示良好的协同作用[3]。
总之,治疗肠球菌感染,应根据耐药特点及菌种间的耐药差异来选择相应的治疗方案。
参考文献[1]joels c s, matthews b d, sigmon l b, et al. clinical characteristics and outcomes of surgical patients with
vancomycin-resitant enterococcal infections [j]. am surgeon,2003,69(6):514.[2]li g x, ding m w, chen l z. in vitro antibacterial activity of quinupristin/dalfopristin against gram positive cocci [j]. chin j antibiot (中国抗生素杂志),2003,28(8):504.[3]wang y p, wang m y. study on the drug resistance of enterococci and countermeasures [j]. guangxi med j (广西医学),2002,24(1):59。